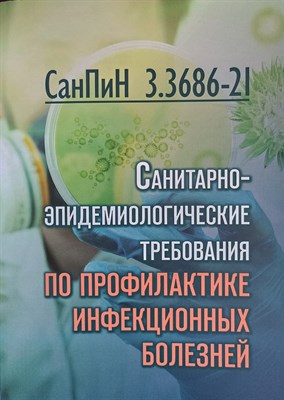

Санитарно эпидемиологические требования к организациям для детей и молодежи - 2023
Санитарно эпидемиологические требования к организациям для детей и молодежи - 2023
Санитарно эпидемиологические требования к организациям для детей и молодежи
Автор:
Год издания: 2023
Тип переплёта: Мягкий
Код: S010447 - Р
Издательство: Проспект
Состояние: Новое
-
Год издания2023
-
ИздательствоПроспект
-
КодS010447 - Р
-
СостояниеНовое
-
Страниц64
-
Тип переплётаОбложка